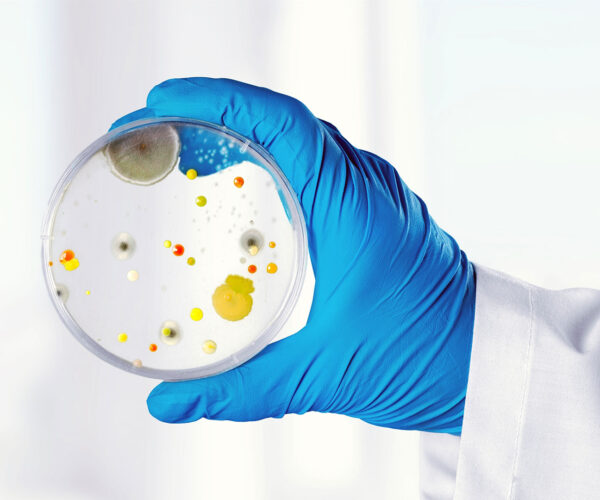

laborax Laboratory Testing
Modern Laboratory Reliable Research.
Our laboratory team applies technical knowledge and validated procedures to deliver controlled, high‑quality analytical performance.
laborax Trusted Scientific
Skilled Scientists Driving Research
Our laboratory team applies technical knowledge and validated procedures to deliver controlled, high‑quality analytical performance.
Analytical Testing
Perform precise chemical, biological, and physical analyses for reliable results.
Sample Analysis
Accurately examine and process samples to ensure reliable and consistent results.
Molecular Research
Explore genes, proteins, and cellular processes with advanced lab techniques.
About Our Laboratory
Advancing Science Through Research
Opening Hours:
12+



Trusted Leaders in Laboratory Excellence
We are a modern laboratory dedicated to discovery and innovation. Using advanced techniques, we analyze samples, study molecular processes, and deliver reliable results that make a difference. Science, precision, and integrity guide everything we do.
Our Lab Expertise
Scientific Research and Laboratory Services
Precision Testing You Can Trust
We provide accurate and reliable laboratory testing and research, using advanced techniques to support scientific discovery and healthcare solutions.
Accurate & Reliable
Our accredited laboratory ensures precise test results you can count on.
State-of-the-Art Equipment
Utilizing advanced instruments for cutting-edge scientific analysis.
Experienced Scientists
A team of experts dedicated to quality research and testing.
-
Visit Our Lab 5th Street, 21st Floor, New York
-
Appointment & Reports (888) 4567890
Schedule a Research
Book Your Diagnostic Testing Appointment
Meet the Scientists
Our Dedicated Team of Scientists and Specialists
“Our research depends on precise, reliable data, and this laboratory has consistently delivered beyond our expectations. From complex assays to routine testing, their team demonstrates expertise at every stage. We particularly appreciate the thorough documentation they provide, which makes integrating results into our research seamless. Working with them has significantly improved both the speed and confidence of our projects.”

Scarlett Reid
“We were new to some of the specialized testing required for our project, and the lab’s staff guided us step by step. They were responsive to every question and provided detailed explanations, making a complex process feel manageable. Their proactive communication and willingness to troubleshoot challenges meant our study stayed on track, and we never felt in the dark about progress or results.”

Nichole Haley
“Our research depends on precise, reliable data, and this laboratory has consistently delivered beyond our expectations. From complex assays to routine testing, their team demonstrates expertise at every stage. We particularly appreciate the thorough documentation they provide, which makes integrating results into our research seamless. Working with them has significantly improved both the speed and confidence of our projects.”

Scarlett Reid
“We were new to some of the specialized testing required for our project, and the lab’s staff guided us step by step. They were responsive to every question and provided detailed explanations, making a complex process feel manageable. Their proactive communication and willingness to troubleshoot challenges meant our study stayed on track, and we never felt in the dark about progress or results.”

Nichole Haley
Professional Laboratory Packages
Invest in Your Health with Our Diagnostic Package
Routine Tests
$32
/sample- Routine Testing & Analysis
- Fasting Blood Sugar
- Blood Glucose Test
- Urinalysis Report
- Digital Report Delivery
Advanced Tests
$68
/sample- Liver Enzyme Assessment
- Renal Function Evaluation
- Thyroid Hormone Profile
- Vitamin D & B12 Levels
- Detailed Physician Notes
Premium Test
$99
/sample- Full Body Diagnostic Screening
- Diabetes Monitoring Panel
- Hormonal Balance Testing
- Priority Lab Processing
- Expert Medical Consultation